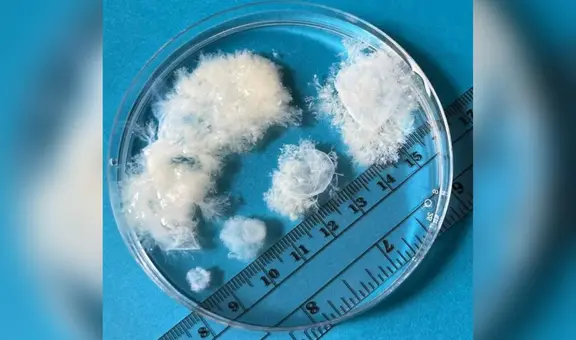
¿Cómo luce un feto antes de las 10 semanas? Científicos lo muestran en imágenes reales

Pleno del Congreso aprueba proyecto de ley que convierte al concebido en sujeto de derecho
En primera instancia, con 60 votos a favor, 27 en contra y 19 abstenciones, el Pleno del Congreso aprobó el texto sustitutorio del proyecto de ley 785, que propone reconocer derechos al concebido por encima del derecho a decidir de las mujeres.
- Gobierno de Jerí continúa sin presentan Plan Nacional de Seguridad en medio de crisis de inseguridad ciudadana
- Ollanta Humala: Fiscalía abre investigación contra jueces que sentenciaron al expresidente y Nadine Heredia

El Congreso aprobó, en primera votación, el proyecto de Ley N.° 785 presentado por la congresista de Renovación Popular Milagros Jáuregui de Aguayo. El dictamen reconoce al concebido el derecho a la vida, salud, integridad moral, psíquica y física, identidad, libre desarrollo, bienestar, entre otros. Además, lo dispuesto en el presente PL añade que se considera como concebido desde la unión de un óvulo y un espermatozoide, lo cual ocurre antes de la implantación en el útero.
Luego de 60 votos a favor, 27 en contra y 19 abstenciones, el Parlamento dio luz verde a la nueva legislación que minimiza el derecho a decidir de las mujeres y otras personas con capacidad de gestar y busca definir el concepto de “concebido” para que sea tomado en cuenta como "persona humana" y se le otorgue derechos como persona jurídica.
TE RECOMENDAMOS
RAFAEL LÓPEZ ALIAGA Y KEIKO FUJIMORI LIDERAN INTENCIÓN DE VOTOS | SIN GUION CON ROSA MARÍA PALACIOS
PUEDES VER: Revisa los candidatos y sus planes de gobierno

Sin embargo, luego de la votación, el proyecto de ley se ha pedido en reconsideración por las congresistas Sigrid Bazán (JP), Ruth Luque (JP) y Susel Paredes (Partido Morado).
¿Qué propone la ley del concebido?
El proyecto de ley aprobado, en primera instancia, indica que el concebido es sujeto de derecho, el cual se fundamenta en la dignidad humana y se extingue cuando muere. “Son derechos del concebido, el derecho a la vida, salud, integridad moral, psíquica y física, identidad, libre desarrollo, bienestar y otros derechos que le favorezcan”, agrega.

Congresistas votaron en contra para que la 'ley del concebido' regrese a la Comisión de Justicia y Derechos Humanos. Foto: Congreso.
También se indica que en casos de alto riesgo médico o peligro en la vida de la mujer y del concebido, compete “a la madre o cónyuge, conviviente o parientes hasta el segundo grado de consanguinidad y primero de afinidad” decidir sobre la aplicación del aborto terapéutico.
¿Cómo sustentaron este proyecto de ley?
El presidente de la Comisión de Justicia y Derechos Humanos, Américo Gonza (Perú Libre), se encargó de sustentar la ley del concebido ante el Pleno del Congreso. “Luego de analizar la inconveniencia de dicha propuesta en vista que establecer como persona humana otorga no solo derechos fundamentales al concebido, sino también una serie de derechos patrimoniales y capacidades de goce y ejercicio, que no pueden regularse con el único cambio del artículo 1 del Código Civil”, señaló.
Asimismo, la legisladora María Jáuregui Martínez (RP), quien propuso la ley, dijo que el concebido tiene derecho a la vida, integridad y desarrollo bienestar. La congresista Rosangella Barbarán Reyes (FP) propuso una cuestión previa para que el dictamen regrese a Comisión para un mejor análisis, pero su propuesta fue rechazada.
El congresista Alejandro Cavero Alva, de Avanza País, dijo que el proyecto es importante, que favorece al concebido. El congresista Edward Málaga Trillo (NA), por su parte, propuso una cuestión previa para que el proyecto de ley regrese a comisión de Salud para un mejor análisis; sin embargo, la propuesta no trascendió.